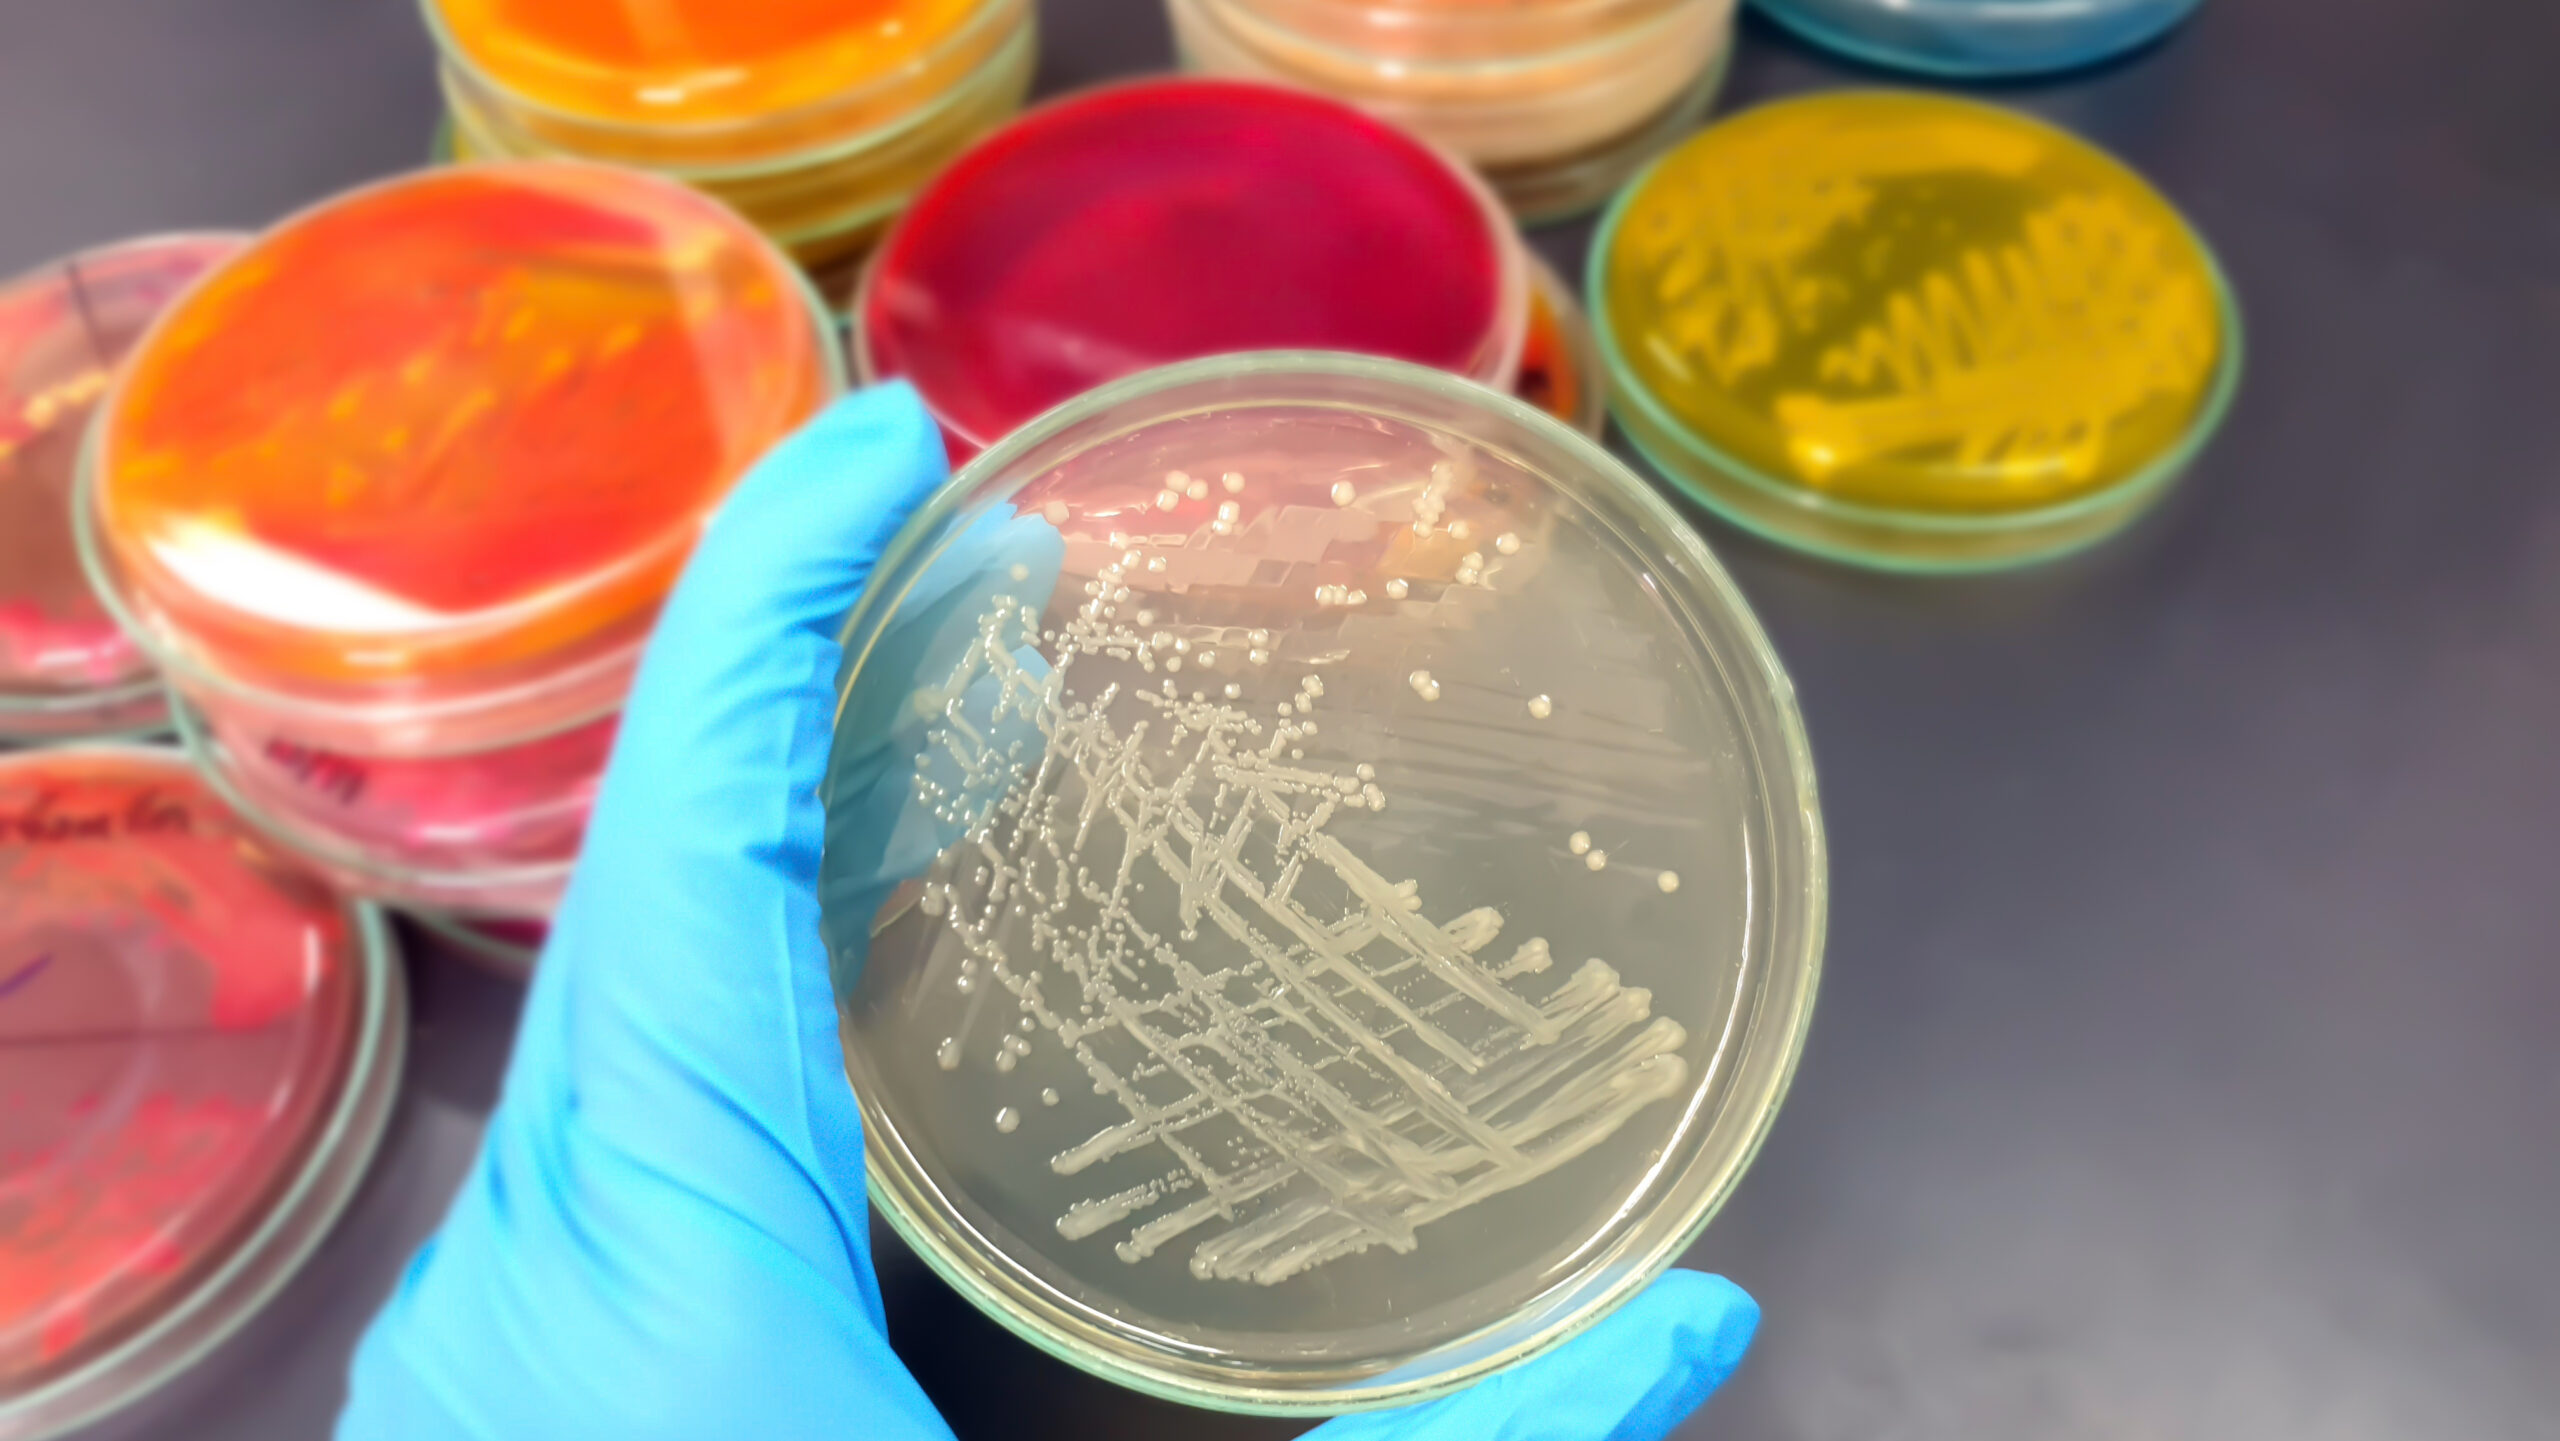
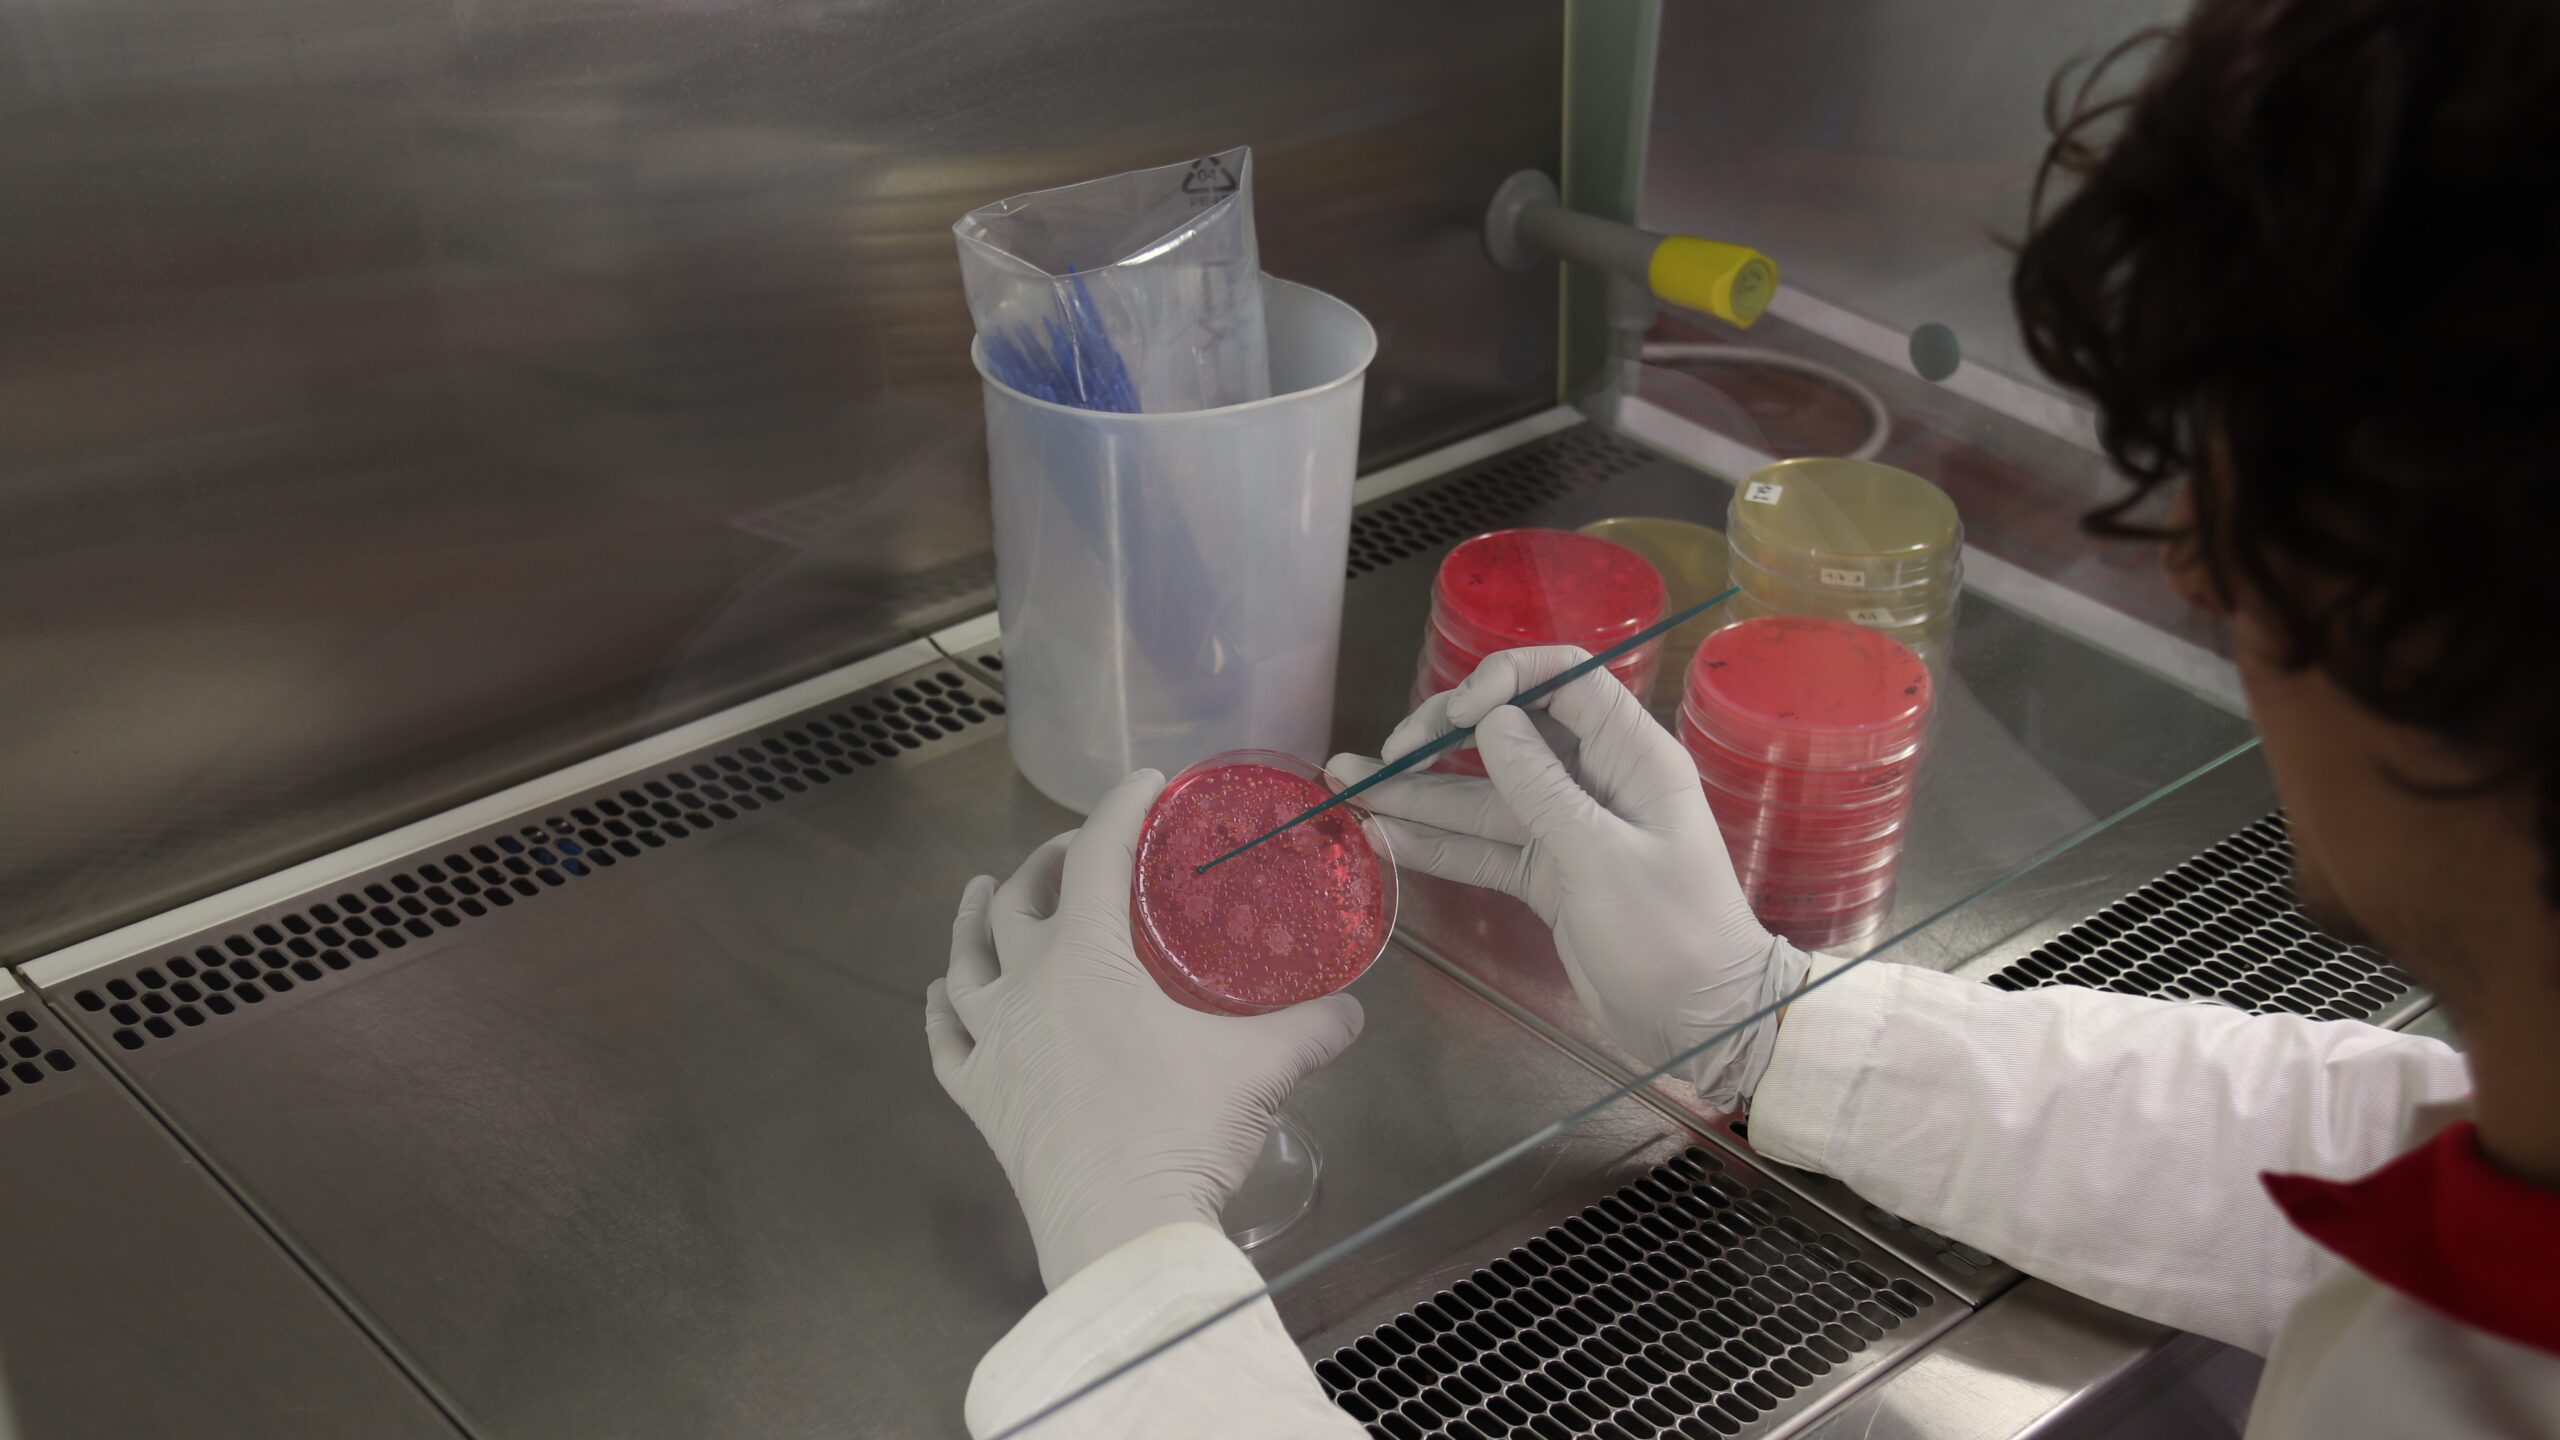
Foto: Ilvo

Voor abonnees Snelle en alternatieve labmethoden: toepassing in de praktijk (videolezing)
Op de Praktijkdag Microbiologie op 10 oktober 2025 spraken Adrie Atsma (Vitens waterexpertisecentrum), Stephen Antonie-Zijlstra (FrieslandCampina) en Monique Haarman (Qlip) over snelle en alternatieve methoden. Ze gaven een overzicht en voorbeelden van nieuwe toepassingen in de praktijk. VMT-abonnees kijken hier de videolezing terug.